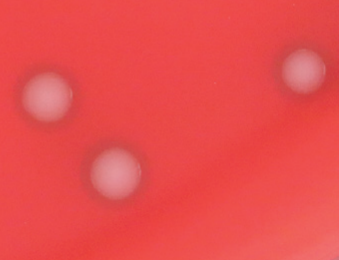
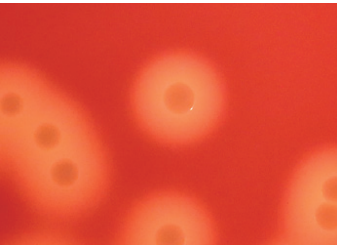
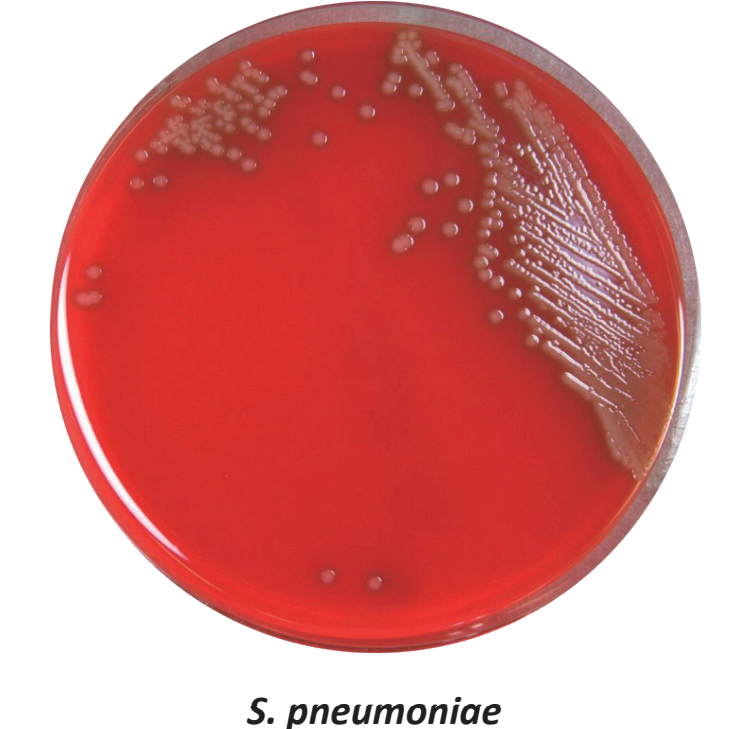
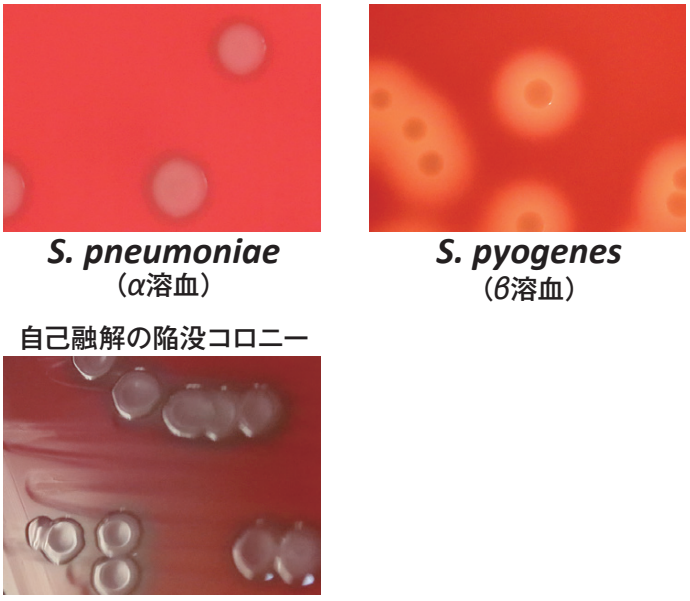
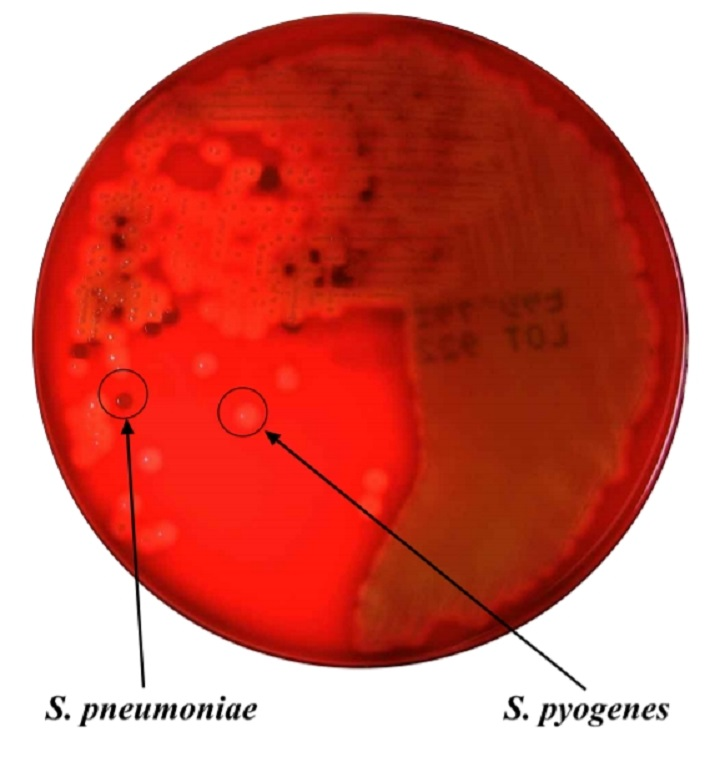
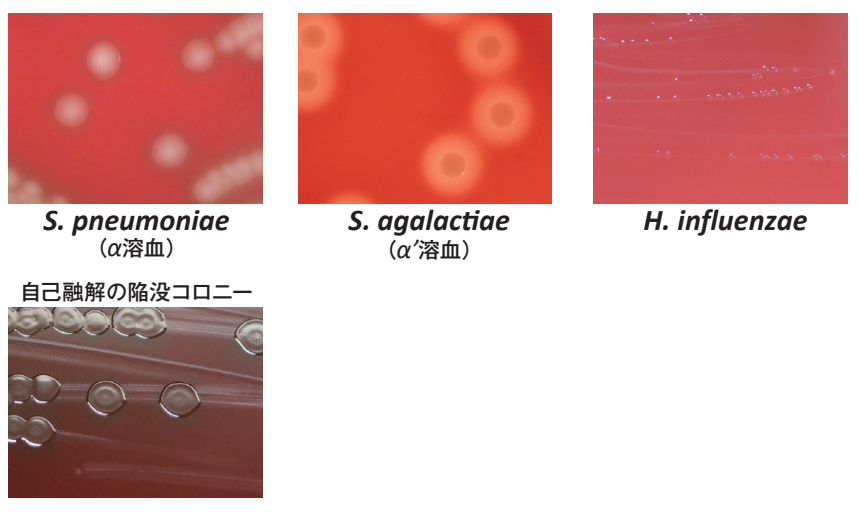
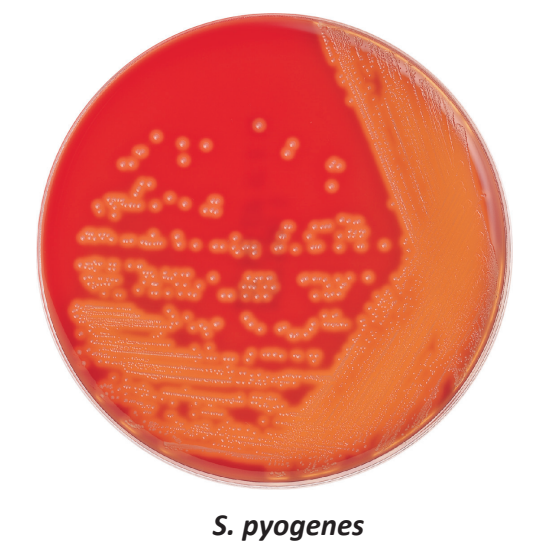
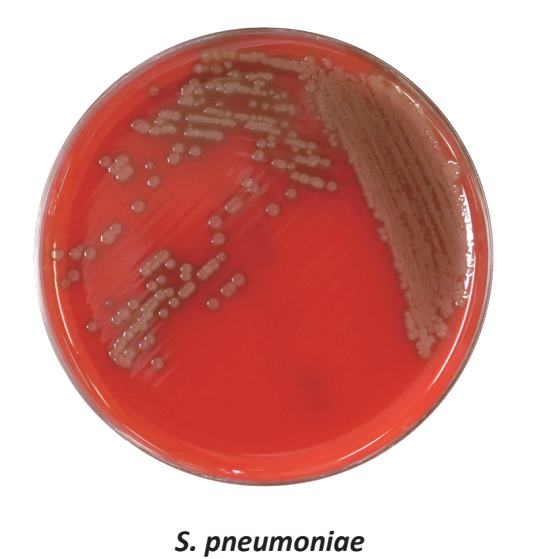
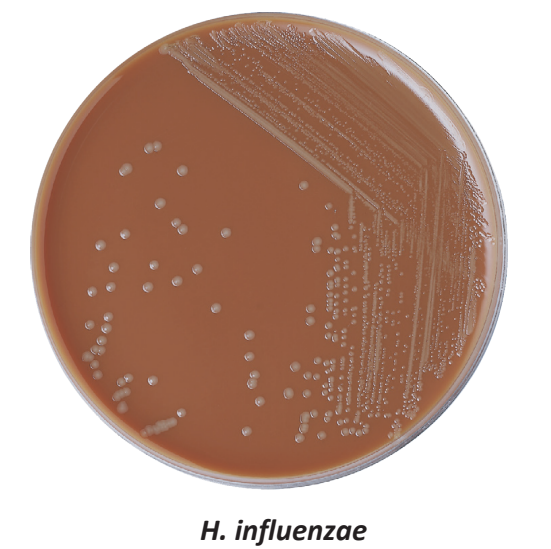
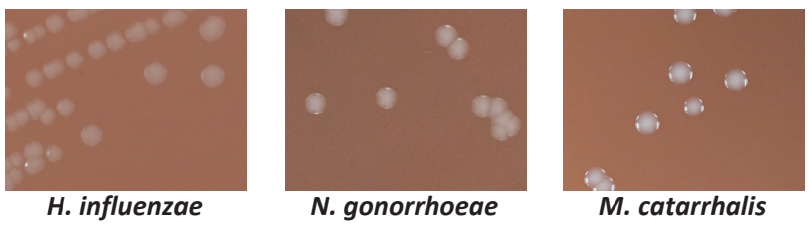
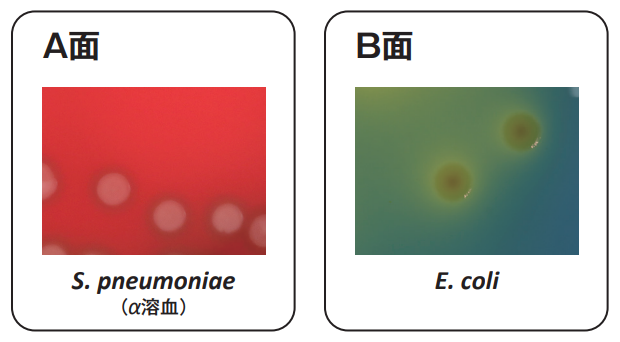
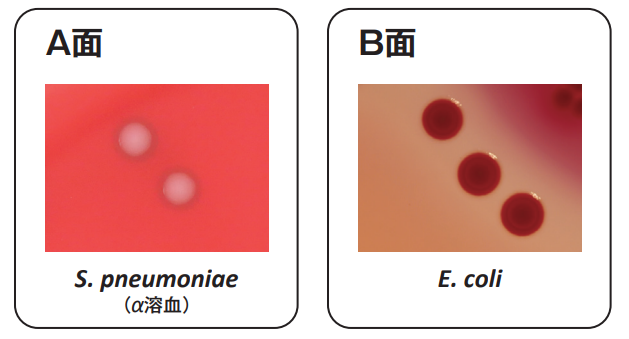
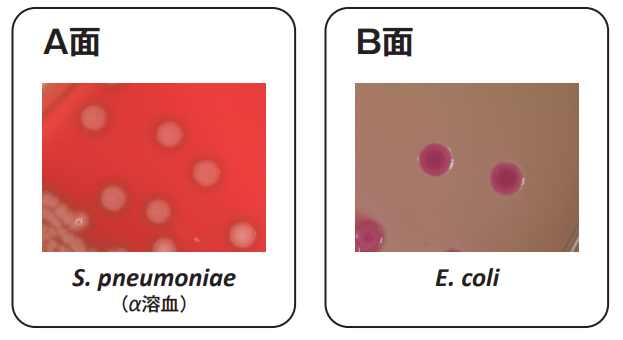
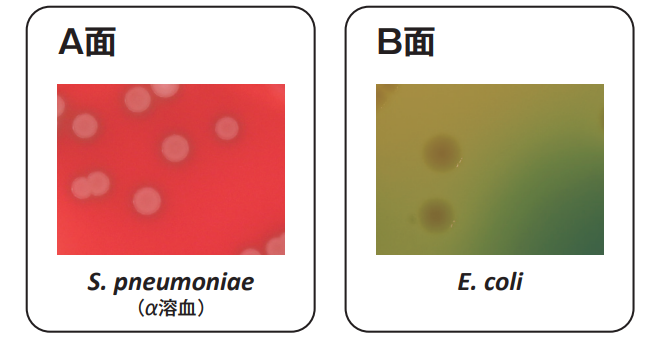
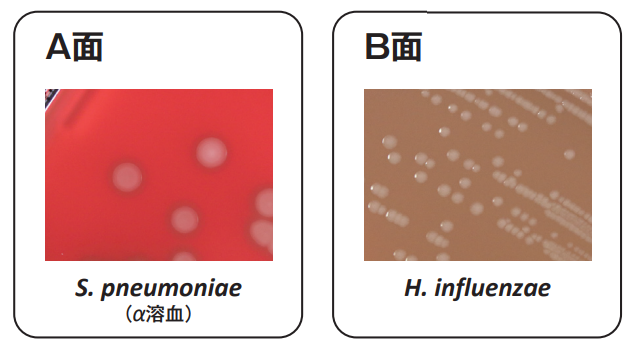
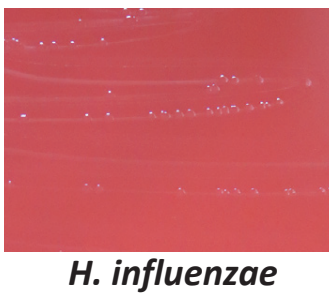

羊血液寒天培地シリーズの
選び方
羊血液寒天培地は、細菌の分離培養や溶血性の観察に用いられる微生物検査の基本的な培地です。本ページでは、目的に応じた羊血液寒天培地の特長や使い分けを整理し、フローチャート形式で選択のポイントをわかりやすくご紹介いたします。日々の検査業務における培地選択の参考としてご活用いただけます。
羊血液寒天培地とは
羊血液寒天培地は、臨床検査において病原菌の分離や溶血性の判定に用いられる最も基礎的な培地のひとつです。
主にレンサ球菌(Streptococcus 属)に以下のような特徴的なコロニーや溶血性を示す培地で、初代分離培養でもレンサ球菌の特徴的なコロニーが観察可能です。
| 溶血性 | 特徴 | 菌 |
|---|---|---|
| α溶血 | コロニーの周囲が緑変 | Streptococcus pneumoniae |
| β溶血 | コロニーの周囲が明瞭な境界を持つ透明な溶血環 | Streptococcus pyogenes |
| γ溶血 | 非溶血(コロニー周囲に溶血環なし) | Enterococcus faecalisなど |
羊血液寒天培地の選び方

※フローチャート末端の製品名をクリックするとページ内の製品紹介へジャンプします。
各種培地の詳細や比較資料等は以下をご参照ください。
アキュレート™ 羊血液寒天培地 (10枚入り)(100枚入り)
基礎培地にトリプトソーヤ寒天培地を用い、ヒツジ脱繊維血液を5%と発育因子を加えた培地
基礎培地:トリプトソーヤ寒天培地
添加 :5%ヒツジ脱繊維血液、発育因子
特に、肺炎球菌(Streptococcus pneumoniae)に対する発育支持力が優れており、集落は大きく溶血性も明瞭に出現します

※Dゾーンテスト(D-zone test)のTSA supplemented with sheep blood (5% v/v)に当てはまります
小児や高齢者などに対する肺炎球菌ワクチン接種効果により、ワクチンタイプ(VT)肺炎球菌による侵襲性肺炎球菌感染症は減少した一方で、非ワクチンタイプ(NVT)肺炎球菌の検出が増加し、莢膜型置換が起きています。
一般に、NVT肺炎球菌の中にはコロニー径が小さく、典型的な陥没形態を示さない型が存在するといわれております。
前記のような菌株に対する羊血液寒天培地、羊血液寒天培地HEMでの発育性能を以下に示します。

さらに詳しい情報はこちら「NVT肺炎球菌を用いた羊血液寒天培地の評価」
アキュレート™ 羊血液寒天培地HEM (10枚入り)(100枚入り)
肺炎球菌(Streptococcus pneumoniae)の発育を強化するとともに、
肺炎球菌のα溶血性やA群レンサ球菌(Streptococcus pyogenes)のβ溶血性を明瞭にした培地

比較資料

アキュレート™ 羊血液寒天培地NA (10枚入り)
羊血液寒天培地にニコチンアミド(Haemophilus 属の発育素 V因子)を添加することにより、Haemophilus 属の発育を可能とした培地

アキュレート™ 羊血液寒天培地EX(100枚入り)
羊血液寒天培地にニコチンアミド、β-NADの添加により、Haemophilus 属の分離用培養を可能とした培地

アキュレート™ CA羊血液寒天培地 (10枚入り)(100枚入り)
コリスチン(C)、アズトレオナム(A)添加によりグラム陰性菌を抑制することで、効率的にグラム陽性菌を検出可能とした選択培地
こんなときにおすすめ!
!汚染度の高い検体(濁りの強い尿検体、喀痰、咽頭検体等)の分離
!Proteus 属菌の遊走でお困りの場合(抗菌薬添加により、Proteus 属菌の発育を抑制するため)

アキュレート™ チョコレート寒天培地EXⅡ (10枚入り)(100枚入り)
ゴノコッカス(GC)寒天基礎培地にヘモグロビン末とCLSI M22-A3発育因子を加え、Haemophilus 属、Neisseria 属などの栄養要求性の厳しい菌の発育支持力を強化した培地

まとめ
| 羊血液寒天 | 羊血寒HEM | 羊血寒NA | 羊血寒EX | CA羊血寒 | チョコレートEXⅡ | |
|---|---|---|---|---|---|---|
| S. pneumoniaeに対する発育支持力 | ◎ | ○ | ○ | ○ | ○ | – |
| S. pyogenesのβ溶血性 | ○ | ◎ | ○ | ○ | ○ | – |
| Haemophilus 属の発育 | ✕ | ✕ | ○ | ◎ | ✕ | ◎ |
| 使用期限(製造後) | 2.5ヵ月 | 2.5ヵ月 | 2.5ヵ月 | 2ヵ月 | 2.5ヵ月 | 4ヵ月 |
| 雑菌の多い検体 | △ | △ | △ | △ | ◎ | △ |
分画培地
1枚のプレートに2種類の培地が分注された製品です。
1枚の培地で2つ培地の性状が確認できるため経済的、かつふ卵器や実験台のスペースの節約に役立ちます。
培地と培地の間の隔壁が培地面より低くなっているため、塗抹時に引っかからず塗抹しやすいです。


分画培地のラインナップはこちら
アキュレート™ 分画 羊血液寒天/チョコレートEXⅡ (10枚入り)(100枚入り)


| A面 | B面 |
|---|---|
| 羊血液寒天培地 | チョコレート寒天培地EXⅡ |
| 基礎培地にトリプトソーヤ寒天培地を用い、ヒツジ脱繊維血液を5%と発育因子を加えた培地 | ゴノコッカス(GC)寒天基礎培地にヘモグロビン末とCLSI M22-A3発育因子を加え、発育支持力を強化した培地 |
| ・Streptococcus pneumoniaeに対する優れた発育支持力 ・典型的な陥没コロニーの観察が可能 | ・Haemophilus 属、Neisseria 属などの栄養要求性の厳しい菌の分離培養、および増菌培養 |
アキュレート™ 分画 羊血液寒天/ドリガルスキー改良 (10枚入り)(100枚入り)

| A面 | B面 |
|---|---|
| 羊血液寒天培地 | ドリガルスキー改良(BTB寒天培地とも呼ばれる) |
| 基礎培地にトリプトソーヤ寒天培地を用い、ヒツジ脱繊維血液を5%と発育因子を加えた培地 | BTB(ブロムチモールブルー)を含有した培地 |
| ・Streptococcus pneumoniaeに対する優れた発育支持力 ・典型的な陥没コロニーの観察が可能 | ・腸内細菌目細菌分離用 ・BTBによりグラム陽性菌の発育が抑制される ※選択性が非常に弱いため、ブドウ球菌や腸球菌などの一部のグラム陽性球菌も小さなコロニーを形成しそれらを釣菌できるという利便性がある ・乳糖分解菌 →黄色のコロニー ・乳糖非分解菌 →無色透明のコロニー ※P. aeruginosaは辺縁ラフ状の青色のコロニーを形成する ※酵母様真菌は白色の小さなコロニーを形成する |
アキュレート™ 分画 羊血液寒天/マッコンキー (10枚入り)(100枚入り)

| A面 | B面 |
|---|---|
| 羊血液寒天培地 | マッコンキー寒天培地 |
| 基礎培地にトリプトソーヤ寒天培地を用い、ヒツジ脱繊維血液を5%と発育因子を加えた培地 | グラム陰性桿菌の選択培地 |
| ・Streptococcus pneumoniaeに対する優れた発育支持力 ・典型的な陥没コロニーの観察が可能 | ・胆汁酸によりグラム陽性菌の発育が抑制される ・乳糖分解菌 →レンガ色コロニー(周囲に淡桃色かレンガ色の沈殿を生じる) ・乳糖非分解菌 →半透明のコロニー |

| A面 | B面 |
|---|---|
| 羊血液寒天培地 | DHL寒天培地 |
| 基礎培地にトリプトソーヤ寒天培地を用い、ヒツジ脱繊維血液を5%と発育因子を加えた培地 | Salmonella 属、赤痢菌(Shigella 属)等の鑑別用 |
| ・Streptococcus pneumoniaeに対する優れた発育支持力 ・典型的な陥没コロニーの観察が可能 | ・デオキシコール酸によりグラム陽性菌の発育が抑制される ・SS寒天培地より選択性が弱いため、SS寒天培地上に発育し難い赤痢菌、Salmonella 属が良好に発育する ・乳糖、白糖非分解菌 →無色透明の、SS寒天培地よりは比較的大きなコロニー ・乳糖、白糖分解菌 →培地を酸性化するため、pH指示薬であるニュートラルレッドにより赤色を呈し、デオキシコール酸の析出により不透明なコロニー ・硫化水素産生菌 →黒色コロニーを形成 |
アキュレート™ 分画 CA羊血液寒天/ドリガルスキーEX (100枚入り)

| A面 | B面 |
|---|---|
| CA羊血液寒天培地 | ドリガルスキーEX寒天培地 |
| 抗菌薬を添加し効率的にグラム陽性菌の検出を可能とした選択培地 | BTB(ブロムチモールブルー)を含有した培地 |
| ・コリスチン(C)、アズトレオナム(A)添加によりグラム陰性菌が抑制されるため、効率的なグラム陽性菌の検出を可能とした選択培地 | ・腸内細菌目細菌分離用 ・BTBによりグラム陽性菌の発育が抑制される ※選択性が非常に弱いため、ブドウ球菌や腸球菌などの一部のグラム陽性球菌も小さなコロニーを形成しそれらを釣菌できるという利便性がある ・乳糖分解菌 →黄色のコロニー ・乳糖非分解菌 →無色透明のコロニー ※P. aeruginosaは辺縁ラフ状の青色のコロニーを形成する ※酵母様真菌は白色の小さなコロニーを形成する |
アキュレート™ 分画 CA羊血液寒天/マッコンキーEX (10枚入り)


| A面 | B面 |
|---|---|
| CA羊血液寒天培地 | マッコンキー寒天培地 |
| 抗菌薬を添加し効率的にグラム陽性菌の検出を可能とした選択培地 | グラム陰性桿菌の選択培地 |
| ・コリスチン(C)、アズトレオナム(A)添加によりグラム陰性菌が抑制されるため、効率的なグラム陽性菌の検出を可能とした選択培地 | ・胆汁酸によりグラム陽性菌の発育が抑制される ・乳糖分解菌 →レンガ色コロニー(周囲に淡桃色かレンガ色の沈殿を生じる) ・乳糖非分解菌 →半透明のコロニー |
アキュレート™ 分画 CA羊血液寒天/VCMチョコレートEXⅡ (10枚入り)(100枚入り)

| A面 | B面 |
|---|---|
| CA羊血液寒天培地 | VCMチョコレート寒天培地 |
| 抗菌薬を添加し効率的にグラム陽性菌の検出を可能とした選択培地 | 抗菌薬添加によりHaemophilus 属やNeisseria 属等の検出率を向上させた培地 |
| ・コリスチン(C)、アズトレオナム(A)添加によりグラム陰性菌が抑制されるため、効率的なグラム陽性菌の検出を可能とした選択培地 | ・バンコマイシン添加によりグラム陽性菌の発育が抑制されるため、Haemophilus 属やNeisseria 属等の検出率を向上させた培地 |
よくあるご質問
A. β溶血性をより明瞭にした羊血液寒天培地HEMがおすすめです。
詳細は、β溶血性を示すS. pyogenesの各培地での発育性比較をご参照ください。
A. アキュレート™ 羊血液寒天培地NAまたはEXをお使いください。
違いは、アキュレート™ 羊血液寒天培地NAとEXの比較資料からご参照ください。
A. アキュレート™ 羊血液寒天培地NAとEXの主な違いは、Haemophilus 属菌の発育性と使用期限です。
比較資料はアキュレート™ 羊血液寒天培地NAとEXの比較資料からご参照ください。ご施設様の運用に合わせてお選びください。
A. 一般的な細菌検査を目的とするなら、まずは定番のアキュレート™ 羊血液寒天培地から。
サンプルのご用意もございますので、お気軽にお問い合わせください。
A. アキュレート™ 羊血液寒天培地がDゾーンテスト(D-zone test)のTSA supplemented with sheep blood (5% v/v)に当てはまります。